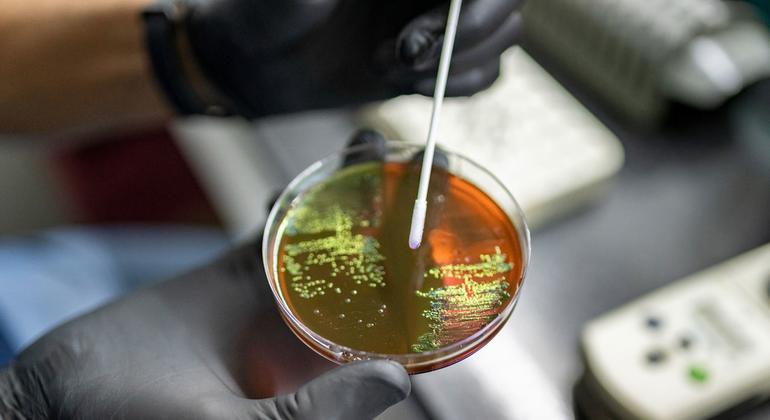

The Southeast Asian country is the most prone to natural hazards in the world, and these hazards are becoming more intense due to climate change. […]
Author: alleuropanws.com
Invest more in vaccines to reduce deaths from drug-resistant superbugs: WHO
AMR occurs when bacteria, viruses, fungi, and parasites change over time and no longer respond to medicines. It is among the top global public health […]
End ‘collective amnesia’ over COVID-19, says UN health agency WHO
Coronaviruses like COVID, influenza and respiratory syncytial virus (RSV) “must be taken seriously” as they are particularly dangerous for at-risk groups including the elderly, pregnant […]
1 in 7 children and teens impacted by mental health conditions
In addition, one-third of mental health conditions emerge before the age of 14 and half before the age of 18. Published ahead of World Mental Health […]
Artificial intelligence: rooting out bias and stereotypes
During High-Level Week of the UN General Assembly in September, the topic of AI was the focus of several side-events featuring industry experts and UN […]
UN rights chief warns of ‘widespread and systematic’ torture of Ukrainian POWs
In a briefing to the UN Human Rights Council on Tuesday, UN rights chief Volker Türk highlighted the widespread devastation and violations of international law […]
Rights expert urges universities to respect pro-Palestinian protests
Gina Romero, Special Rapporteur on the rights to freedom of assembly and association, warned that “the brutal repression of the university-based protest movement is a […]
Gang attack in Haiti’s Pont Sondé leaves 70 dead
Among the victims at the hands of the so-called Gran Grif gang were 10 women and three infants. “As the attacks unfolded, gang members reportedly […]
UN rights council examines nuclear legacy consequences in the Marshall Islands
Research conducted by the UN human rights office, OHCHR, revealed that 67 nuclear tests performed between 1946 and 1958 by the United States Government in […]
The week the world comes to Manhattan: Looking back at UNGA79
Let’s try to unscramble those 10 days for you. This year, some 235 events and hundreds of speakers later, the spotlight was shone on what […]